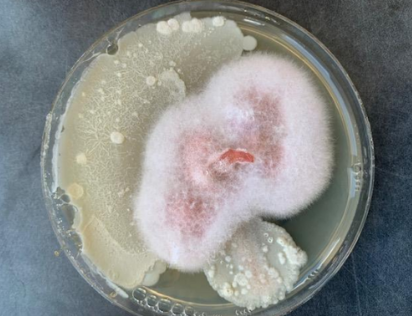
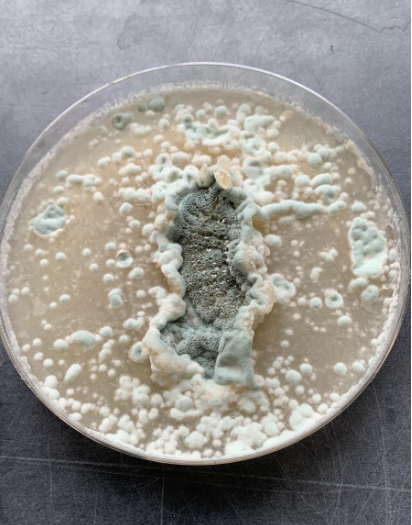

Soluciones Biotecnológicas para una Agricultura Sostenible y Eficiente
En Bio World Organic, revolucionamos la agricultura mediante soluciones biotecnológicas avanzadas que maximizan la productividad y promueven la sostenibilidad. Con nuestra línea de productos, como BWO Agricultura, ayudamos a los agricultores a mejorar el rendimiento de sus cultivos de forma natural, ofreciendo protección contra enfermedades y plagas mediante el poder de los microorganismos vivos.
Beneficios de Nuestras Soluciones:
Sanidad Vegetal Mejorada:
Refuerza las defensas naturales de las plantas contra hongos y nematodos, protegiendo cultivos como cebolla, ajo y manzano.
Mayor Vigor y Crecimiento:
Fomenta un crecimiento más robusto y una cosecha de alta calidad.
Sostenibilidad y Biodiversidad:
Contribuye a un sistema agrícola equilibrado y respetuoso con el medio ambiente, promoviendo una producción sin productos químicos sintéticos.
Testimonios de Nuestros Clientes
"Desde que comenzamos a aplicar BWO Agricultura, nuestros cultivos han experimentado un notable aumento en vigor y resistencia a enfermedades. Ahora, nuestros cultivos crecen más sanos y fuertes." - J.R., Agricultor de la región de Albacete.

Productos Destacados de Bio World Organic para la Agricultura
Descripción:
BWO Agricultura es un producto formulado con microorganismos vivos que mejora la calidad del suelo al restaurar su biodiversidad.
Al trabajar en sinergia con las plantas, optimiza la absorción de nutrientes y favorece un desarrollo vegetal saludable.
Ideal para prevenir y controlar enfermedades fúngicas y ataques de nematodos.

Beneficios de BWO Agricultura en el Control de Plagas y Enfermedades
Inhibición de Fusarium Oxysporum
Con eficacia comprobada, BWO Agricultura actúa como preventivo natural contra Fusarium, protegiendo tus cultivos de raíz rosada y otras enfermedades graves.

Prevención de Raíz Rosada en Cebollas
Al aplicarse desde el inicio del cultivo, previene la aparición de Pyrenochaeta terrestris, manteniendo tus cebollas en óptimas condiciones.
Control de Penicillium en Ajo
Reduce la incidencia de Penicillium en el ajo, promoviendo una producción más sana y de alta calidad.

Protección contra el Moteado del Manzano:
Las pruebas en campo han demostrado que BWO Agricultura previene el moteado (Venturia inaequalis), manteniendo la salud y la productividad del manzano.
Compra BWO Agricultura hoy mismo para proteger tus cultivos y mejorar la sanidad de tu suelo.

Reducción de Nematodos en Cultivos de Ajo y Otros
Resultados Destacados en la Temporada 2023/2024
Al aplicar BWO Agricultura desde el inicio del cultivo, se ha observado una disminución significativa de Ditylenchus dipsaci en ajos, permitiendo una producción más limpia y rentable.
Consulta el informe completo sobre la incidencia de nematodos en cultivos de ajo y otros vegetales.
Nuestra Misión en Bio World Organic
En Bio World Organic S.L., estamos comprometidos con el desarrollo de soluciones que aprovechen el potencial de los microorganismos para transformar la agricultura y mejorar la vida de los agricultores.
Nos especializamos en:
- Agricultura sostenible y rentable
- Productos biológicos para control de plagas y enfermedades agrícolas